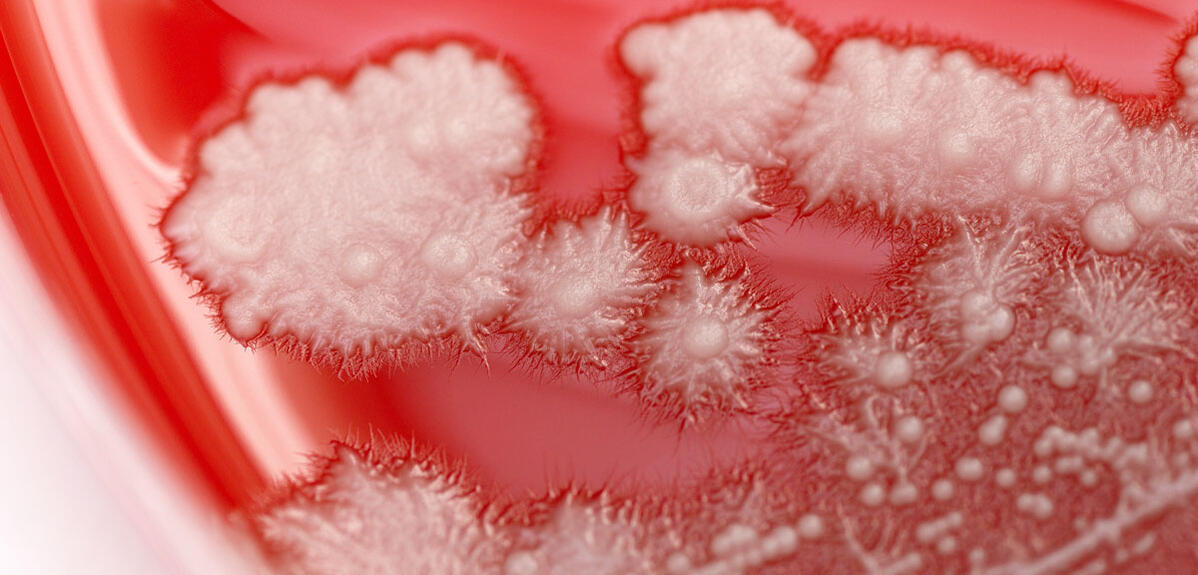
Blocking off highway to infections

For decades, pink granite boulders scattered across the volcanic peaks of the Hudson Mountains in West Antarctica have puzzled scientists. However, a study published in October 2025 may have finally solved the mystery surrounding their origin,…
Author: admin
-
Blocking off highway to infections
By elucidating the mechanism that enables the microscopic fungus “Candida albicans” to cause an infection, a CNRS research team has opened the way towards several new therapeutic opportunities.
How does a normally…
Continue Reading
-

Seal and Sea Lion Brains Help Explore the Roots of Language
Until recently, vocal behavior in animals was assumed to be largely inflexible—a product of inheritance with little influence of learning. Increasingly, though, studies are finding examples of animals that, like humans, have the flexibility to…
Continue Reading
-

Deadly Indonesia landfill collapse a ‘serious warning’ of systemic failure
A 50-meter (164-foot) mountain of waste at Indonesia’s Bantargebang landfill, the country’s largest, recently collapsed following days of extreme rainfall that destabilized the massive, saturated pile. The tragedy resulted in seven confirmed…
Continue Reading
-
Low-cost test dissolves threat of fake drugs
Fake news can be tricky to spot, but spotting fake drugs just got a little easier. Researchers have devised a low-cost way to help distinguish legitimate medications from counterfeit ones.
Continue Reading
-

Stress-activated pathway reveals how nervous system contributes to eczema flare-ups
The mystery of how stress exacerbates atopic dermatitis, more commonly known as eczema, may be closer to being understood. A new study published in the journal Science has identified a specific nerve pathway that helps explain the link.
Continue Reading
-

Roman funerary inscription emerges from mud in Livorno Countryside
A chance discovery in the countryside near Livorno has brought a fragment of ancient Roman life back into the spotlight, after a remarkably well-preserved funerary inscription surfaced from a muddy canal following heavy rains.
The find was made…
Continue Reading
-

Europe Just Restored Contact with a “Lost” Spacecraft After Weeks Adrift, Thanks to A Rare Alignment
A silent spacecraft drifting in space has been brought back into contact, restoring momentum to one of Europe’s most intricate solar missions. After nearly a month without communication, engineers managed to reconnect during a brief and…
Continue Reading
-

AI startups are eating the venture industry and the returns, so far, are good
Well, the data is out. AI startups accounted for 41% of the $128 billion in venture dollars raised by companies on Carta last year — a record-high annual share. In a sense, though, we knew that. Investors last year were voracious in deploying…
Continue Reading


